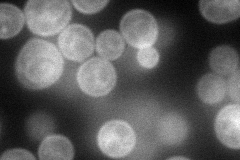
YGR152C
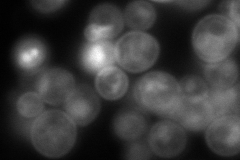
YGR152C
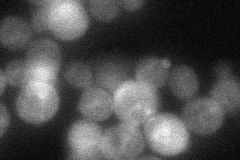
YGR152C
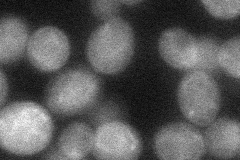
YGR152C
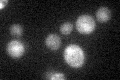
YGR152C

View description
GTP-binding protein of the ras superfamily required for bud site selection, morphological changes in response to mating pheromone, and efficient cell fusion; localized to the plasma membrane; significantly similar to mammalian Rap GTPases
Localization:
Intensity:
Fold change:
Significance:
-
C’ GFP library in SD

cytosol36.45 -
N' NOP1pr-GFP in SD
cell periphery,ER88.4116 -
N' TEF2pr-mCherry in SD
cell periphery,vacuole160.728 -
N' NATIVEpr-GFP in SD
ambiguous,cell periphery49.553 -
N' TEF2pr-VC and Cyto-VN in SD
cytosol41.4052 -
C’ GFP library in SD+DTT

cytosol36.030.98No -
C’ GFP library in SD+H2O2

cytosol36.721No -
C’ GFP library in Starvation Media
cytosol36.931.01No -
C’ GFP library on the background of Pup2-DaMP

cytosol -
C’ GFP library on the background of CCT mutant

cytosol28.70510.78723No
